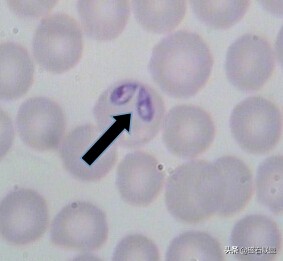
潜藏在蜱虫身上的“暗影”：犬巴贝斯虫的危害远比蜱虫要大得多
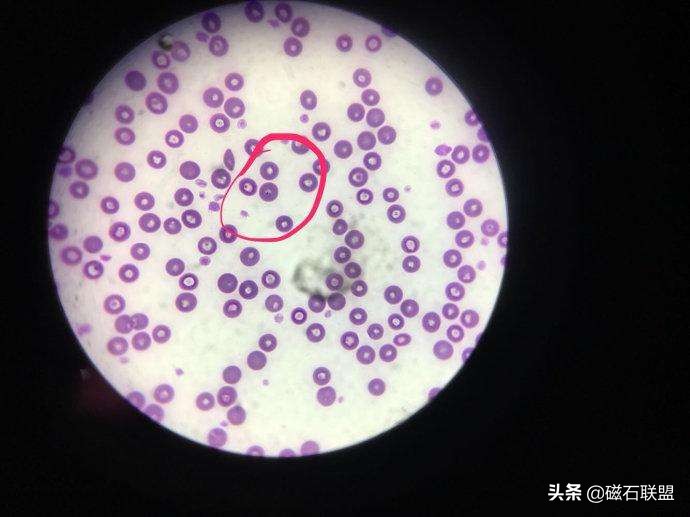
潜藏在蜱虫身上的“暗影”：犬巴贝斯虫的危害远比蜱虫要大得多

养犬困扰多,还看磁石说~
秋季是狗狗体外寄生虫病的高发季节,由于狗狗经常在户外进行活动,所以患上寄生虫疾病的概率大大提升。
很多经常关注宠物知识的主人们都知道需要定时给狗狗做体内、外的驱虫,而体外寄生虫主要以蜱虫、跳蚤为主。

那么,你听说过犬巴贝斯虫吗?
什么是犬巴贝斯虫?
犬巴贝斯虫是寄生在犬的红细胞中的血液性原虫,主要寄生于蜱虫体内,通过蜱虫叮咬犬只来进入犬只的血液内进行繁殖寄生。

犬巴贝斯虫主要可分为两种类型:
- 犬巴贝斯虫:虫体很大,一般为4 ~ 5μm,最长的可达7μm。在红细胞中大多呈双梨形排列,2个虫体的尖端以锐角相连。在红细胞中的虫体数目较多,有的会达15个。
- 吉氏巴贝斯虫:虫体很小,位于红细胞边缘或偏中心,呈长圆形、小杆形、圆点形、环形,偶尔可见十字架形的四分裂虫体或成对的小梨籽性虫体,以圆点形、环形及小杆形最多。

犬巴贝斯虫多发于春季及秋季,尤其是经常出入灌木丛中的工作犬、散养犬和未经过驱虫的犬只,一般在户外7~10天即会感染巴贝斯虫并发病。
巴贝斯虫会在犬只体内长期生存,甚至可通过遗传直接传染给新生小狗。
感染巴贝斯虫的症状
犬巴贝斯虫病主要症状是黄疸、高热、呼吸困难,这主要与快速贫血和缺氧有关,幼犬往往易感染上该疾病,缺乏及时治疗甚至会导致死亡。

病程如下:
- 初期经过2~10天的潜伏期之后,发病时体温会迅速升高,在短时间内可达到40~43℃的高温,并伴随精神虚弱、眼膜成淡红色乃至发绀。
- 中期体温恢复正常,但仍可能出现不规则间歇性发热,开始出现贫血、结膜苍白、精神萎靡甚至食欲废绝、黄疸等症状。
- 后期可能会出现肾脏肿大、腹泻、蛋白尿并伴随着呕吐、腹泻等症状。
- 严重时可产生急性肾衰、中枢性神经障碍、凝血异常和急性胰腺炎等并发症,若患病犬能够成功耐受过病程,则会在3~6周内恢复正常,并且可获得长达2~5年的对症免疫。

如何诊断犬巴贝斯虫病
对于犬巴贝斯虫病可从流行病学和临床症状作出基本判断,最终确诊需要通过一系列的实验室筛查。
实验室检查
- 血常规检测:患上犬巴贝斯虫的狗狗血细胞将会减少,血红蛋白降低,在镜检下可能会出现幼红细胞与多染红细胞增加的红细胞再生镜像。
- 尿液检查:可能会出现静置后红细胞沉淀的血尿与静置后仍然均匀的血红蛋白尿。
- 显微镜检查:染色后可在显微镜下见到犬巴贝斯虫或吉氏巴贝斯虫的形态。
临床诊断
当患病犬有被蜱虫叮咬的历史并且体温升高至40~43℃、可视粘膜呈淡红色、黄疸并且出现尿血、贫血等症状,则可初步推断为犬巴贝斯虫病。
犬巴贝斯虫的治疗
由于犬巴贝斯虫属于传染性寄生虫疾病,不及时治疗甚至可威胁患病犬生命,所以需要得到及时的重视及治疗。
主要治疗原则分为对症治疗与支持疗法。

对因治疗:
- 使用抗原虫药物例如阿奇霉素,口服阿奇霉素(10mg/kg),可有效抑制、清除巴贝斯虫,但值得注意的是该药有一定的胃肠道副作用,胃肠道脆弱的犬只慎用。
- 血虫净,该药为巴贝斯虫较为常用的治疗药物,需要进行肌肉注射3~5mg/kg;由于会刺激胃肠道及注射部位肿胀等且清除虫体不够完全,所以该药需谨遵医嘱使用。
支持疗法:
用地塞米松诱发增殖型虫体,用*丸睾**酮兴奋骨髓造血功能、提高红细胞生成素产生,促进红细胞的发育和成熟。病犬血色素在30 g /dl以下时要配合输血疗法或血液代用品( 5%以下) 。

该病病程较长(至少15天以上),且容易复发,所以需要做好愈后照料及驱虫。
犬巴贝斯虫如何预防
由于目前没有治疗犬巴贝斯虫的特异*药性**物,所以预防犬感染巴贝斯虫病就显得尤其重要,磁石联盟将在以下为大家罗列预防犬巴贝斯虫的方法。
环境管理(灭蜱)
由于犬巴贝斯虫主要是通过蜱虫叮咬进行传播,所以我们需要对狗狗平时生活的环境做好定期的消毒、杀虫,有庭院的家庭还要做好除草的工作。
消除环境中犬巴贝斯虫对于狗狗的隐患。

控制传染源
我们需要严格控制自家的狗狗与患病狗接触、避免传染,对于家中已有的患病犬只应该实行隔离饲养,同时也应该限制狗狗在春秋季节的外出活动区域,少踏足草地等存在感染源的区域。

驱虫预防
犬巴贝斯虫的中间宿主为蜱虫,传播需要蜱虫叮咬犬只,所以最好的预防方法及时给狗狗做体外驱虫。
市场上一般的驱虫药物如非泼罗尼都可以起到体外驱虫的预防作用,一般8周龄的狗狗即可进行体外驱虫,每月一次。
除此之外定时清洁狗狗、给狗狗洗澡也是预防犬巴贝斯虫的重要一环。

犬巴贝斯虫看起来很可怕,但它只是潜藏在蜱虫身上不敢见光的一个“弱者“,只要主人们提高警惕,防范于未然;
自然就没有这种烦恼,所以,还在等什么呢?
快带你的狗狗去驱虫吧。